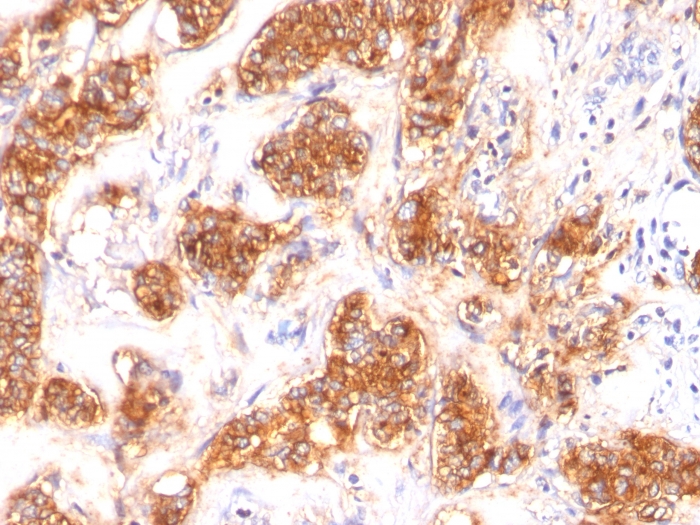

Formalin-fixed, paraffin-embedded human Breast Carcinoma stained with Milk Fat Globule Monoclonal Antibody (SPM291)

Formalin-fixed, paraffin-embedded human Renal Cell Carcinoma stained with Milk Fat Globule Monoclonal Antibody (SPM291).

Formalin-fixed, paraffin-embedded human Pancreas stained with Milk Fat Globule Monoclonal Antibody (SPM291)
Recognizes a protein of 40-45kDa, identified as human milk fat globule membrane protein (HMFG). HMFG is present on normal human breast epithelial cells and cell lines derived from breast carcinomas, as well as to the outer surface of the human milk fat globule. HMFG is considered as a differentiation marker. It is useful as specific breast epithelial marker and can also provide a tool to study the role of the cell surface in normal and neoplastic mammary development.
There are no reviews yet.